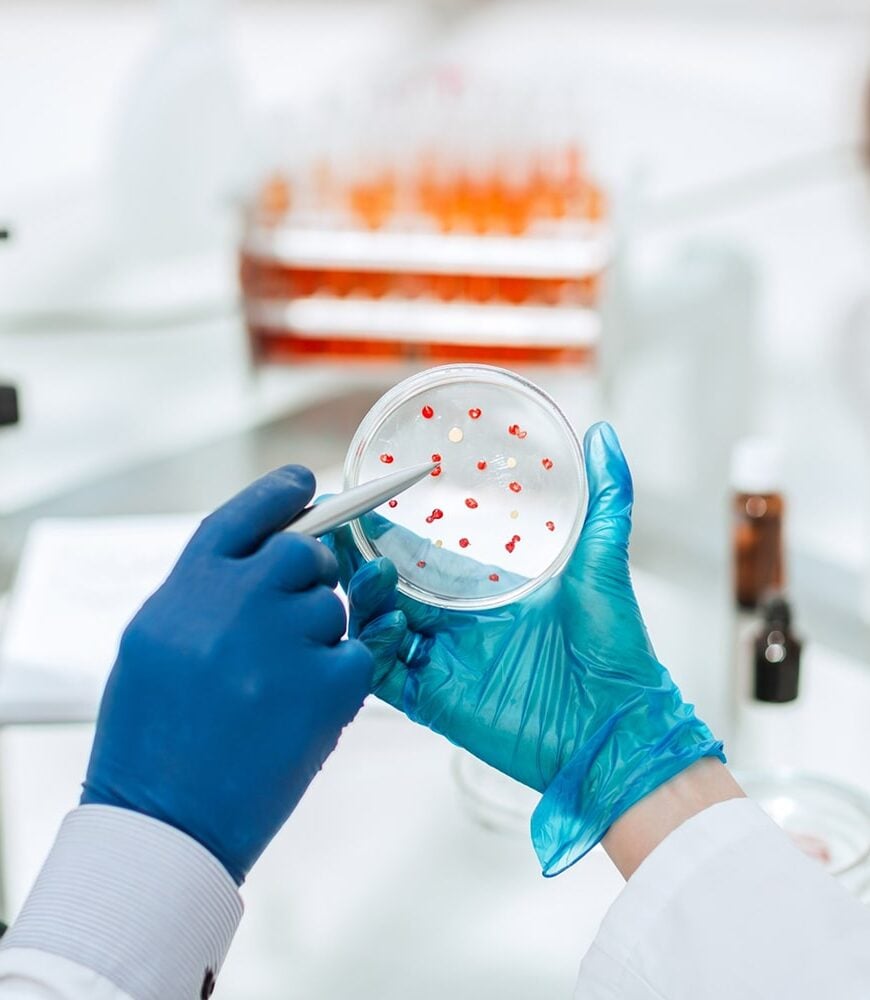

Who We Are
With a global reach our firm has
been business since 1998.
Our Service
We deliver precision
in every service
How it works
We strive to transform patient care through research
Sample Collection
We begin with a quick pre-wash inspection to identify dirt levels, paint condition attention.
Experimentation
Using high-pressure water jets, we rinse away loose dirt and debris from the car’s surface.
Reporting
We begin with a quick pre-wash inspection to identify dirt levels, paint condition attention.
Safety Disposal
Using high-pressure water jets, we rinse away loose dirt and debris from the car’s surface.

Clinical Solutions
We deliver precision
in every service
We believe that everyone deserves to feel confident and empowered every
single day. Our mission is to provide products services, and support
mission is to provide exceptional Accounting.
single day. Our mission is to provide products services, and support
mission is to provide exceptional Accounting.
Testimonials
Experiences.
Biggest challenges in biology.
4.9
30000+ People
Trusting us!

Our Projects
Pioneering research projects that push the boundaries of discovery and Innovation.

3 m +
27 +
98 %
50 k +
Our Pricing
Plans
-
Basic Plan
Kick off your journey with basics creativity -
Standard Plan
Unlock Premium assets and on-brand visuals -
Premium Plan
Boost your creativity with full access